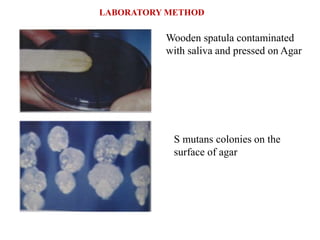
Wooden spatula contaminated
with saliva and pressed on Agar
S mutans colonies on the
surface of agar
LABORATORY METHOD

This document discusses caries risk assessment tools and factors. It introduces several tools used to assess caries risk: the Caries Risk Assessment Tool (CAT), Caries Management by Risk Assessment (CAMBRA), Cariogram, and the Traffic Light Matrix. It describes the various factors each tool considers like biological factors, protective factors, clinical findings, plaque, specific microbes, diet, eating patterns, and saliva. The goal of these tools is to improve oral health by introducing preventive measures before irreversible lesions develop based on a patient's caries risk level and factors.